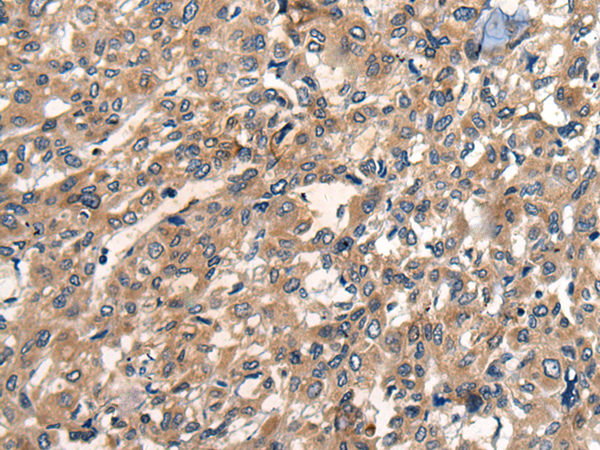

中文名稱: 兔抗OAS3多克隆抗體
英文名稱: Anti-OAS3 rabbit polyclonal antibody
別 名: 2'-5'-oligoadenylate synthetase 3; p100; p100OAS
相關類別: 一抗
抗 原: OAS3
儲 存: 冷凍(-20℃)
宿 主: Rabbit
反應種屬: Human
標 記 物: Unconjugate
克隆類型: rabbit polyclonal
技術規格
|
Background: |
This gene encodes an enzyme included in the 2', 5' oligoadenylate synthase family. This enzyme is induced by interferons and catalyzes the 2', 5' oligomers of adenosine in order to bind and activate RNase L. This enzyme family plays a significant role in the inhibition of cellular protein synthesis and viral infection resistance. |
|
Applications: |
ELISA, IHC |
|
Name of antibody: |
OAS3 |
|
Immunogen: |
Synthetic peptide of human OAS3 |
|
Full name: |
2'-5'-oligoadenylate synthetase 3 |
|
Synonyms: |
p100; p100OAS |
|
SwissProt: |
Q9Y6K5 |
|
ELISA Recommended dilution: |
5000-10000 |
|
IHC positive control: |
Human liver cancer |
|
IHC Recommend dilution: |
25-10 |
購物車
購物車 幫助
幫助
 021-54845833/15800441009
021-54845833/15800441009
